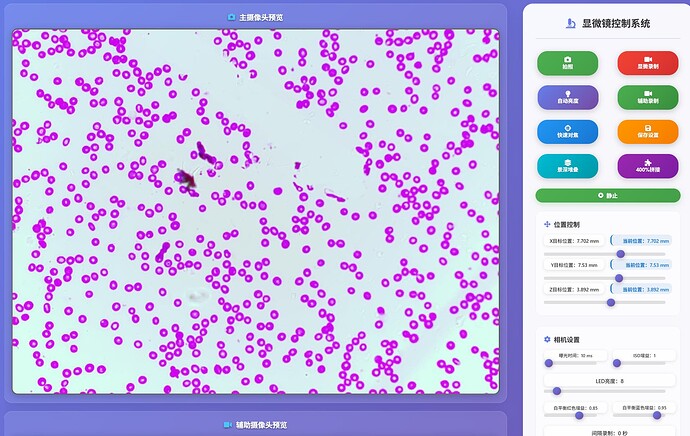
image

Hello, everyone,
Inspired by the impressive microscope design, I built one and do some custom design. My goal is to create a low-barrier, high-precision microscope. Our team includes PhDs in optics and AI, but we work on this in our spare time. We hope to further explore this open-source project and eventually sell it to both DIY enthusiasts and professional customers.
Here are our microscope structure, we using raspi5 with 2 cameras, the IMX219 above the stage using for monitor, more convenient for users to place and monitor samples, recognize the objective magnification by labels(red cicrcle),and other functions to be develop.
IMX477(HQ) camera using for imaging with larger field of view. we design the pcb with independent power supply (though the design to power the Raspberry Pi directly has not yet been realized), It powers three motors, two LEDs, three Hall sensors, and an ADS1115 chip, using three LDO regulators. ADS1115 chip is using for monitor three hall sensors for position about 15 um error.
next step, we will make the system control working at any public network, and adding agent control functions. If you have any suggestions, please don’t hesitate, Thanks !